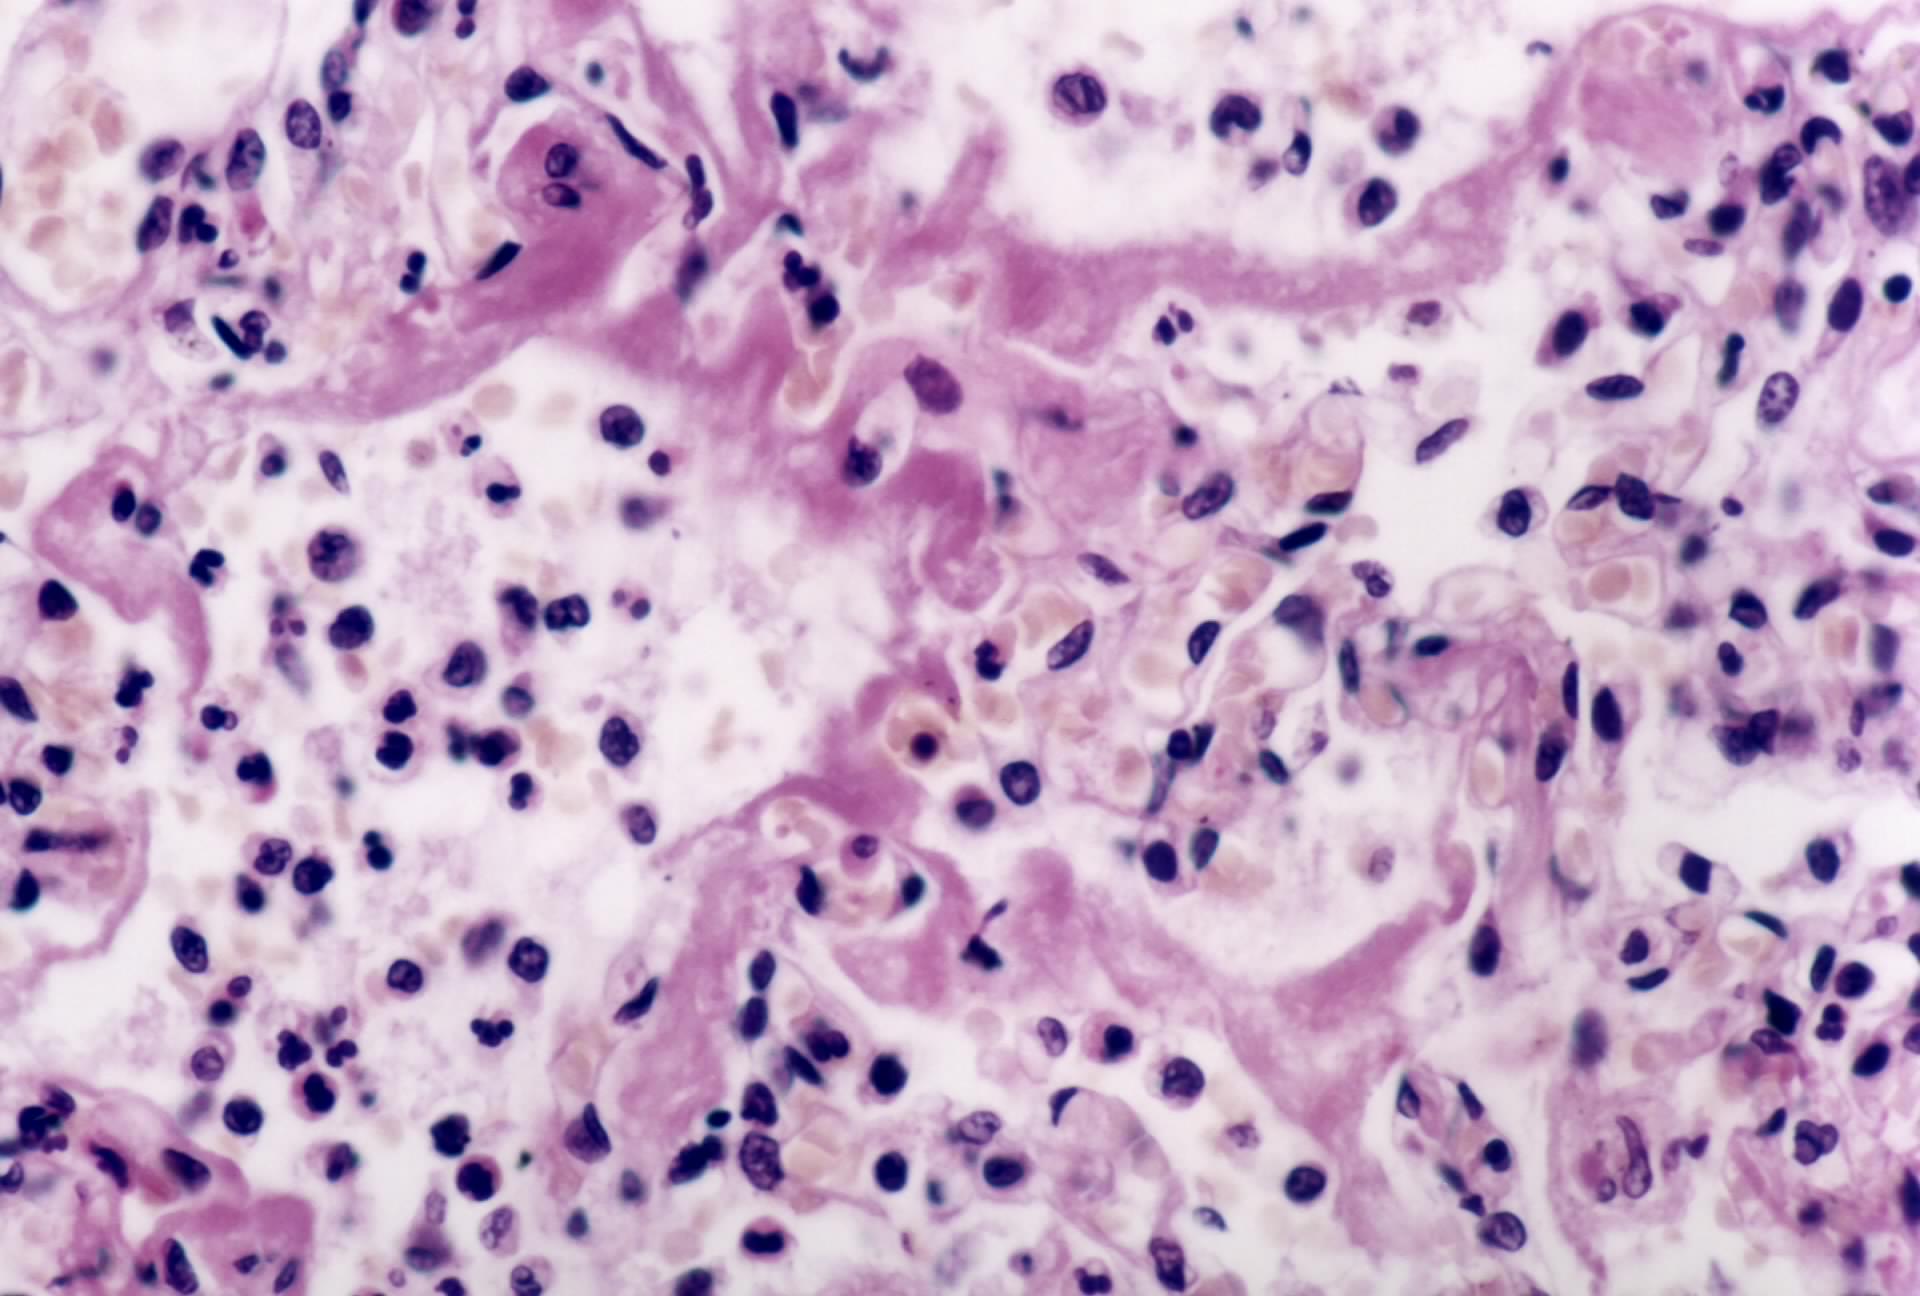
肺泡囊

肺泡切片图

肺泡40
图片尺寸657x492
肺泡管
图片尺寸1920x1296
上面一张是慢阻肺,下面一张是正常的 请问上图有支气管吗 肺泡的
图片尺寸3273x2856
肺大泡
图片尺寸600x800
胸腔镜下肺大泡切除术
图片尺寸2000x2667王兆宇:正常肺组织,肺泡间隔纤细王兆宇:小叶间隔王兆宇:肺动脉和支
图片尺寸1280x960
左肺下叶肺大泡切除标本
图片尺寸800x600
组胚切片复习全部结构
图片尺寸1080x810
左肺下叶肺大泡切除标本
图片尺寸800x600肺泡囊
图片尺寸1920x1296
弥漫性肺泡损伤的分期_北京东城中医医院
图片尺寸496x394
肺切片
图片尺寸800x600
如何区分肺泡上皮细胞与炎症细胞?
图片尺寸2560x1920
在进行永久切片检查时,肺泡中填充组织细胞.
图片尺寸598x469肺泡囊
图片尺寸1920x1296
可参考 断诊断 肺切片 细支气管充血 中性粒细胞浸润 肺泡间隔破坏
图片尺寸1440x810肺泡管
图片尺寸800x600
病理学实验切片考试题图集答案ppt
图片尺寸1080x810
肺泡软部肉瘤
图片尺寸1012x718
如何分离纯的肺泡上皮细胞?
图片尺寸600x415